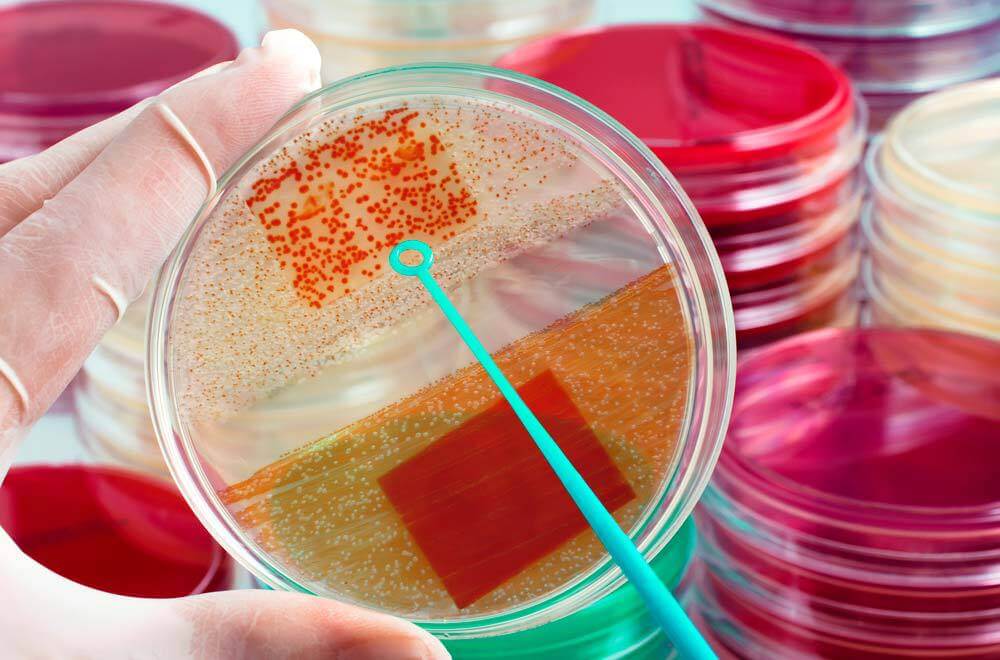
analise clinica de bactérias, representando a meningite bacteriana

Febre súbita, dor de cabeça e rigidez no pescoço são alguns sinais de alerta para essa doença extremamente grave que pode levar a pessoa à morte. Quer entender o que é meningite bacteriana, como preveni-la e muito mais? Leia o nosso post completo!
O que é meningite bacteriana?
A meningite bacteriana é uma inflamação das meninges, as membranas que envolvem o encéfalo (cérebro, bulbo, cerebelo e a medula espinhal) causada pela presença de bactérias.
É uma síndrome grave que pode levar à morte. Por esse motivo, se surgirem sintomas de meningite, deve-se procurar atendimento médico o mais rápido possível.
Veja alguns tipos de bactérias que causam a meningite bacteriana:

Existem outros tipos de meningite?
Além da meningite bacteriana, existem outros 4 tipos da doença: meningite viral, por fungos, protozoários e helmintos.
Como se pega meningite bacteriana?
A transmissão da meningite bacteriana ocorre de pessoa para pessoa por meio de gotículas e secreções do nariz e da garganta expelidas durante a fala, espirro ou tosse. É importante informar que algumas pessoas podem transportar as bactérias causadoras da doença em seus corpos mesmo se não estiverem doentes.
Outra forma de transmissão é por meio de alimentos, como é o caso da transmissão das bactérias Escherichia coli e Listeria monocytogenes.
Quais são os fatores de risco?
Crianças com menos de 5 anos, principalmente as menores de 1 ano, têm mais probabilidade de desenvolver em meningite. No tipo causado pela bactéria Neisseria meningitidis, o risco é maior em crianças, adolescentes e jovens adultos e é agravado em casos de surto da doença.
- Saiba mais: O que é meningite pneumocócica?
Por que a meningite bacteriana é mais grave do que a viral?
Porque a maioria das meningites virais são benignas e evoluem sem precisar de tratamento. Já as bacterianas podem ser graves e devem ser tratadas com antibióticos imediatamente.
Qual é o período de incubação da doença?
Os primeiros sintomas de meningite costumam aparecer de 3 a 4 dias depois do contágio.
Sintomas e sinais da meningite bacteriana
Os sintomas da meningite bacteriana começam com febre de forma súbita, dor de cabeça e rigidez do pescoço. A evolução da doença em adultos costuma ser bem rápida, com piora em pouquíssimas horas. Geralmente, a pessoa infectada dá entrada em algum hospital de 24h a 48h depois do surgimento dos primeiros sinais.
Outros sintomas da meningite bacteriana são:
- Aumento da sensibilidade à luminosidade (fotofobia);
- Confusão mental;
- Enjoo /náusea;
- Mal-estar;
- Vômito.
Os sinais podem ficar graves e evoluir para:
- Coma;
- Convulsão;
- Delírio;
- Tremor.
Caso um bebê esteja com a doença, talvez seja difícil perceber os sinais que descrevemos acima, mas a criança pode:
- Parecer irritada;
- Vomitar;
- Não se alimentar bem;
- Parecer que não responde aos estímulos;
- Ter moleira protuberante;
- Reflexos anormais.
Se a pessoa tiver uma infecção na corrente sanguínea causada pela bactéria Neisseria meningitidis, doença chamada de septicemia meningocócica ou só meningococcemia, podem surgir outros sinais além dos descritos acima, como:
- Calafrio;
- Diarreia;
- Dor forte nas articulações, músculos, peito ou barriga;
- Fadiga;
- Pés e mãos frios;
- Presença de manchas vermelhas no corpo;
- Respiração acelerada.
É importante informar que a meningite bacteriana pode ser mortal ou deixar sequelas, como: surdez, dificuldade de aprendizagem e comprometimento cerebral.
Como é feito o diagnóstico da meningite bacteriana?
Sempre que suspeitar de um caso da doença, procure um pronto-socorro para avaliação médica. O profissional da área da saúde pode pedir exame de sangue para avaliar a saúde do paciente, além de um exame líquido cerebroespinhal (líquor). As amostras serão analisadas pelo laboratório para verificar qual é o agente causador da meningite. Desse modo, o médico vai saber como tratar especificamente a infecção.
É muito importante se consultar sempre com um médico de sua confiança, principalmente caso haja suspeita de alguma doença, além de investigar como anda sua saúde.
Como tratar a meningite bacteriana?
Por causa da gravidade da doença, os pacientes com quadro suspeito sempre são internados nos hospitais. O tratamento da meningite bacteriana é feito com antibióticos e essa medicação deve ser administrada em ambiente hospitalar.
Meningite bacteriana tem cura?
Sim, a meningite bacteriana tem cura. Porém, a pessoa precisa procurar um hospital assim que os primeiros sintomas aparecerem.
Como prevenir a meningite bacteriana?
Para algumas bactérias causadoras da meningite, existe a possibilidade de prevenção por meio da vacinação e da quimioprofilaxia. Os imunizantes estão disponíveis para proteger contra as principais causas da doença. Veja quais são:
- BCG;
- Meningocócica ACWY ou C;
- Meningocócica B;
- Pneumocócica 10 (VPC10) / 13 (VPC 13) ou 23 (VPP23):
- Pentavalente ou Hexavalente.
Outras maneiras de prevenção são: evitar aglomerações e manter os ambientes sempre limpos e ventilados.
Médicos respondem:
Quando a meningite pode matar?
A meningite tem mais chance de levar a óbito quando a procura por um serviço médico não ocorre de forma ágil, a partir do início dos sintomas. Dessa forma, é muito importante que, a qualquer sintoma apresentado, o paciente prontamente procure por uma assistência médica para avaliação. Ainda assim, implementada a antibioticoterapia em tempo adequado, a letalidade dessa condição pode ser alta.
Os grupos de risco para mortalidade são: pacientes com idade avançada, rebaixamento do nível de consciência, além de hemocultura positiva e plaquetopenia.
Quanto tempo dura a meningite bacteriana?
A duração varia de acordo com a evolução clínica de cada paciente. Sabe-se que, de acordo com cada bactéria específica, é utilizado antibioticoterapia adequada, variando no período de tratamento.
Proteja-se contra a meningite bacteriana no conforto da sua casa. Chame a Beep!
As vacinas BCG, Pentavalente, Hexavalente, Meningocócica ACWY, Meningocócica B, Pneumocócica 13 (VPC 13) e 23 (VPP23) estão disponíveis na Beep. O melhor? A nossa equipe vai até você, de domingo a domingo.